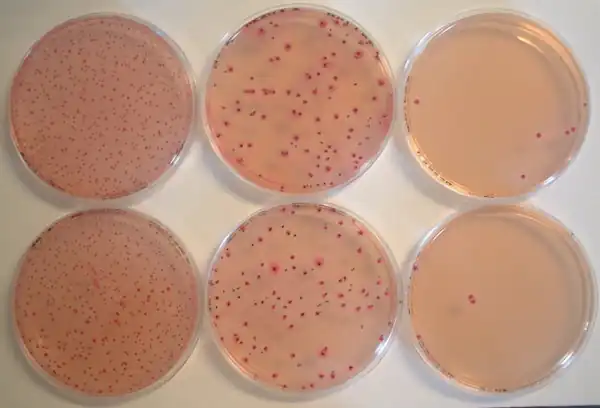

Coliforme
Les coliformes sont des Entérobactérales utilisant le lactose par respiration ou fermentation avec production de gaz à 30 °C en 48 h. Les coliformes sont donc des bacilles Gram négatif, non sporulants, oxydase négative, aéroanaérobies, capables de cultiver en présence d'inhibiteurs de Gram - (sels biliaires, désoxycholate, tergitol…). Certains coliformes possèdent les mêmes propriétés à 44,5 °C : ce sont les coliformes thermotolérants, autrefois nommés coliformes fécaux[1].
La notion de coliforme est essentiellement utile en microbiologie alimentaire.
Le dénombrement des coliformes (dits totaux) et des coliformes thermolérants est une technique importante utilisée dans l'analyse microbiologique des aliments car les coliformes vivent comme commensaux dans les intestins d'animaux à sang chaud (comprenant les humains) signant par leur présence une contamination fécale de l'aliment. La mesure de la concentration doit être interprétée en fonction des critères applicable à l'aliment. Il n'y a aucun rapport direct entre leur présence et la pathogénicité éventuelle des coliformes.
Ce dénombrement est en concurrence avec celui des Entérobactéries/Entérobactérales, ensemble regroupant les coliformes (lactose +) et les non-coliformes (lactose -).
Nature des coliformes
Ce groupe est basé sur des propriétés biochimiques et morphologiques et n'entre pas dans la classification conventionnelle des bactéries (taxonomie). La plupart des coliformes sont des Entérobactéries, principalement Escherichia coli, Klebsiella, Citrobacter, Enterobacter. Les coliformes thermotolérants sont avant tout Escherichia coli parfois Klebsiella.
Techniques utilisées pour le dénombrement et l'identification des coliformes totaux et thermotolérants
Le dénombrement des coliformes est utile essentiellement en microbiologie alimentaire.
technique en milieu liquide
Le milieu liquide utilisé est le bouillon bilié au vert brillant additionné d'une cloche incubé à 30 °C conditionné en tube.
La bile et le vert brillant permettent la sélection des bactéries Gram négatif. La cloche recueille les gaz produit par fermentation anaérobie du lactose dans le milieu (dioxyde de carbone, dihydrogène). La positivité du tube ensemencé montre donc la présence initiale de un coliforme au moins dans l'inoculum et sa négativité l'absence de coliforme.
Pour assurer le dénombrement, plusieurs tubes (3 ou 5) sont ensemencés pour chacune des dilutions du produit analysé : une table du nombre le plus probable (NPP) permet de conclure (technique de Mac Grady).
Afin de savoir si les coliformes détectés dans les tubes positifs sont des coliformes thermotolérants, un repiquage est réalisé dans un BLBVB et une eau peptonée. Après incubation à 44,5 °C, les tubes de BLBVB permettent d'affirmer la présence de coliformes thermotolérants dans le tube incubé à 30 °C. L'eau peptonée, additionnée de réactif de Kovacs, permet de savoir si ces coliformes thermotolérants produisent de l'indole, caractéristique d'Escherichia coli.
La technique en milieu liquide, très consommatrice en matériel, est aujourd'hui obsolète bien qu'elle soit la seule à mettre en évidence les gaz produits.
technique en milieu solide
Le dénombrement des coliformes totaux et thermotolérants utilise une gélose au désoxycholate et cristal-violet (inhibiteurs de la plupart des Gram positifs), du lactose et un indicateur de pH le rouge neutre qui, par sa couleur rouge signe l'utilisation du lactose sans que l'on puisse distinguer s'il s'agit de fermentation ou de respiration.
L'inoculum est placé dans une boite de Pétri puis recouvert de la gélose en surfusion et mélangé. Une double couche fine est ajoutée au dessus après solidification, évitant l'envahissement éventuel de la gélose, assurant une certaine anaérobiose et facilitant le comptage des colonies. La réalisation pour les dilutions du produit analysé de boites incubées à 30 °C ou 44,5 °C permettra de conclure le dénombrement.
Pour les eaux, la concentration microbienne étant très faible, la technique utilise une filtration sur membrane suivie du dépôt du filtre sur une gélose lactosée au tergitol 7 (tensioactif inhibiteur).
identification
L'identification des coliformes a utilisé une technique classique, le test IMVIC, obsolète aujourd'hui.
test IMVIC
Il s'appuie sur :
- I : pour production d'indole à partir de tryptophane,
- MR ou RM (méthyl red) : pour acidification du milieu par fermentation en 48 hdu glucose en acides organiques (voie des acides mixtes), acidification révélée par le virage au rouge cerise du colorant rouge de méthyle (rouge orangé),
- VP (Voges-Proskauer), test qui manifeste la capacité métabolique à neutraliser l'acidification du milieu, lors de la fermentation, en produisant du butanediol,
- (Inositol) rarement réalisé.
- C : pour utilisation du citrate dans un milieu où la seule source de carbone est du citrate de sodium.
- (TTC pour Chlorure de Triphényl Tétrazolium) rarement réalisé
E. coli est habituellement indole +, RM +, VP -, Citrate de Simmons -

identification moderne
Chaque colonie identifiée est repiquée sur une gélose ordinaire incubée à 37 °C et éventuellement une eau peptonée puis identifiée soit sommairement (oxydase, indole) soit plus précisément par une microgalerie comme la galerie API20E®. Interviennent dans le choix l'intérêt de l'identification et son coût.
L'utilisation d'un milieu d'isolement comme la gélose EMB peut permettre une identification directe.
Applications
Les coliformes sont recherchés dans les aliments et dans les eaux de consommation humaine car ils comprennent de nombreux microorganismes d'origine fécale et sont des marqueurs de l'hygiène des aliments et de l'eau. Mais du fait de la présence de coliformes non fécaux, le dénombrement des seuls Escherichia coli, dont l'habitat est quasi exclusivement intestinal est préféré. Pour les eaux, le dénombrement des entérocoques, anciennement appelés "Streptocoques fécaux", est aussi utilisé comme indicateur de contamination fécale.
Notes et références
- Christiane et Jean-Noël Joffin, Microbiologie alimentaire, Bordeaux, CRDP d'Aquitaine (Canopée), 2014 (5e édition), 418 p. (ISBN 978-2-8661-7515-3)
- Portail de la microbiologie